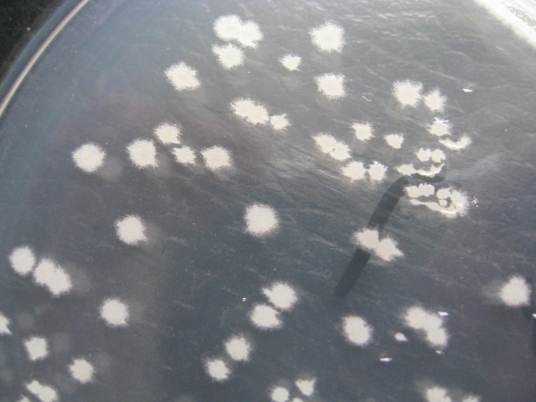
枯草芽孢杆菌B-91

枯草芽孢杆菌B-91
的有关信息介绍如下:
枯草芽孢杆菌B-91(Bacillus subtilis B-91),孢囊不显著膨大,芽孢椭圆或柱形,中生到端生,革兰氏阳性。使柑桔发生柑桔青、绿霉病。
想要了解更多“枯草芽孢杆菌B-91”的信息,请点击:枯草芽孢杆菌B-91百科
枯草芽孢杆菌B-91(Bacillus subtilis B-91),孢囊不显著膨大,芽孢椭圆或柱形,中生到端生,革兰氏阳性。使柑桔发生柑桔青、绿霉病。
想要了解更多“枯草芽孢杆菌B-91”的信息,请点击:枯草芽孢杆菌B-91百科